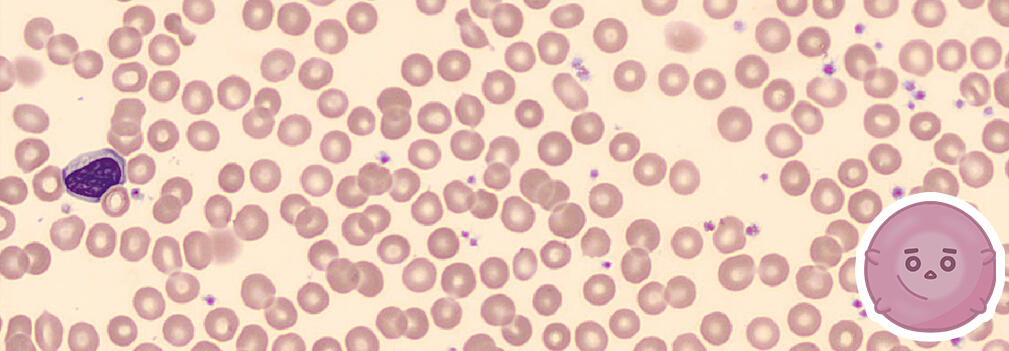
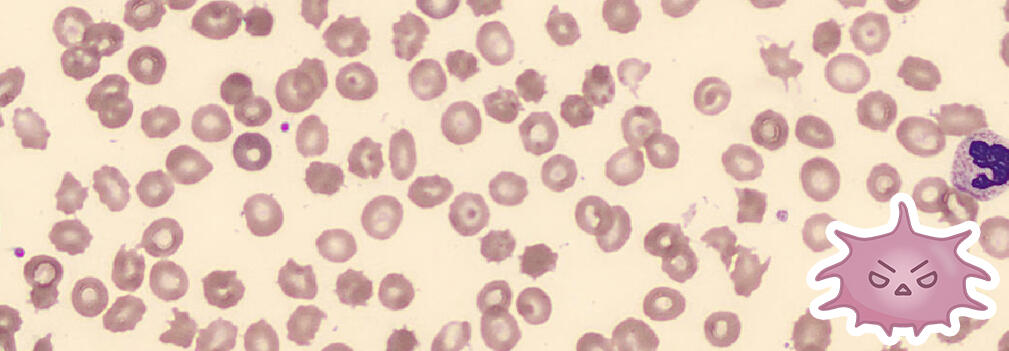
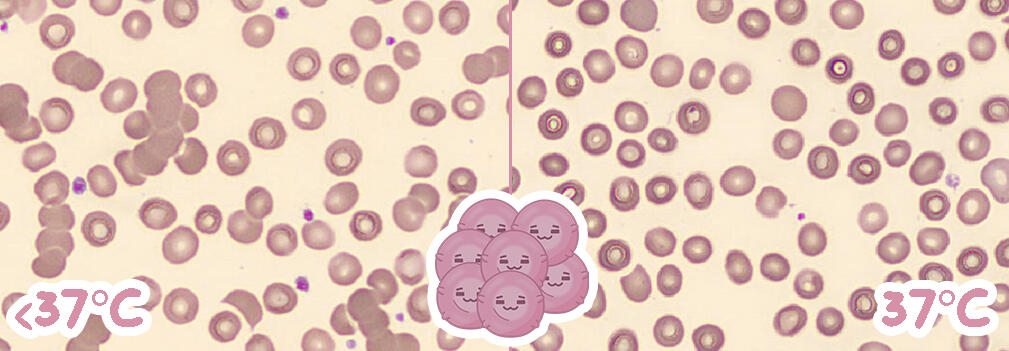
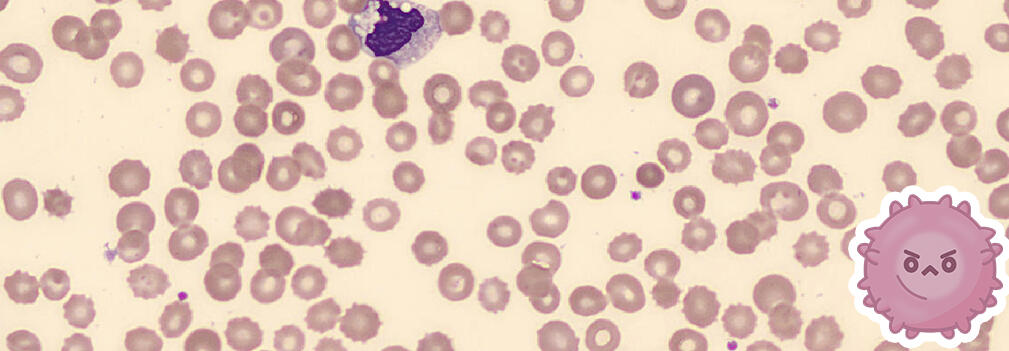
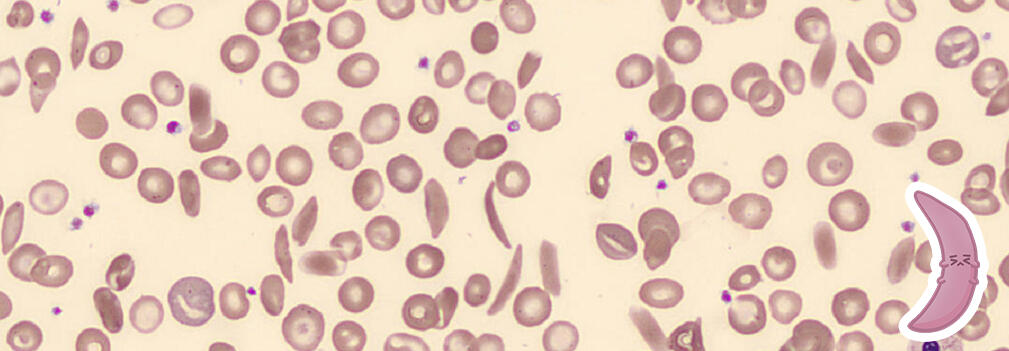
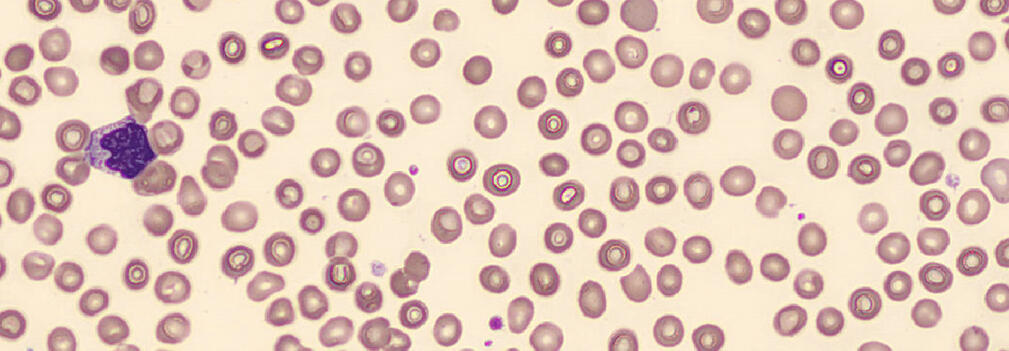

Transports oxygen and carbon dioxide in the body
A biconcave disc shape with no nucleus (6.2–8.2 µm)
The shape allows for flexibility in navigating the circulatory system
Appears as a circle with a central pallor under light microscopy
Has a lifespan of 120 days
Contains hemoglobin, a protein containing iron that is responsible for binding oxygen and transporting some carbon dioxide, in the cytoplasm
Normocytic normochromic anemia occurs when the red blood cells are normal in colour and shape, this may occur secondary to other conditions or diseases
• Abnormally shaped red blood cells with irregular thorny projections
○ Spicules vary in size, shape and distance from each other and
○ Caused by alterations in cholesterol, phospholipids, and structural proteins of the cell membrane
• Found in:
○ Liver Disease - Caused by increased membrane cholesterol
○ Abetalipoproteinemia - Caused by increased membrane lipids (increased sphingomyelin)
○ Neuroacanthocytosis syndromes & McLeod Syndrome - Caused by an absent structural protein
○ Post-splenectomy
○ Myeloproliferative Disorders
○ Microangiopathic hemolytic anemia
• Grape-like clusters of red blood cells
• Due to IgM autoantibodies that bind to red cell antigens
• Causes:
○ Idiopathic
○ Occur after an infection against the I or i antigen - Viral (Epstein-barr) or Mycoplasmal
○ Due to a lymphoproliferative disorder against the I or i antigen
• At <37℃ (4℃):
○ IgM autoantibodies bind to red cell antigens and cause agglutination
○ IgM also activates complement-medicated hemolysis
○ Intravascular and extravascular hemolysis
○ Spherocytes
○ MCHC >375
• At 37℃ (body temp or incubation):
○ IgM autoantibodies detach from red blood cells
○ MCHC may correct to <375
• Abnormally shaped red blood cells with evenly spaced blunt projections or “burrs”
○ The cell’s central pallor is maintained
• Can be formed artifactually due to in vitro factors such as:
○ Old blood samples stored at 4℃
○ Smear preparation - slow drying blood, pH of glass slide
○ Excess EDTA (underfilled tube)
• Found in:
○ Pyruvate kinase deficiency - due to intracellular ATP depletion
○ Liver disease - due to RBC surface proteins binding to abnormal HDL
○ Kidney disease - due to a soluble factor
○ Uremia
○ Hyperlipidemia
• Abnormally shaped red blood cells that appear thin and crescent-shaped with pointed ends
• Caused by a point mutation in the β-globin gene on chromosome 11, leading to the production of the less soluble Hemoglobin S
○ Homozygous inheritance
• In low oxygen tension, normal shaped red blood cells deform into a more rigid sickled shape
• Factors such as low oxygen saturation, decreased pH, increased 2,3-BPG and dehydration can cause HbS polymerization
• Rigid sickle cells can cause:
○ Vaso-occlusion
○ Tissue ischemia
○ Infarction
○ Hemolysis
• Abnormally shaped red blood cells with a sharp projection at one end, shaped like a tear. The end is blunted.
• Seen in:
○ Myelofibrosis - Primary or secondary bone marrow fibrosis, leading to mechanical changes in RBC membrane and cytoskeleton
○ Extramedullary hematopoiesis in the spleen - close-meshed spleen sinusoids pinch RBCs and cause teardrops, which can occur in severe hemolytic anemias with increased RBC breakdown in the spleen
• Hematopoietic or metastatic neoplasms - bone marrow infiltration of tumors leads to bone marrow crowding
• Splenic abnormalities
• Vitamin B12 deficiency
Acute Lymphoblastic Leukemia
• Emadi, A., & Law, J. Y. (2023, October). Acute Lymphoblastic Leukemia (ALL) - Hematology and Oncology. Merck Manuals. Retrieved March 12, 2024, from https://www.merckmanuals.com/en-ca/professional/hematology-and-oncology/leukemias/acute-lymphoblastic-leukemia-allAlpha/Beta Thalassemia
• Braunstein, E. M. (2022, June). Thalassemias - Hematology and Oncology. Merck Manuals. Retrieved March 12, 2024, from https://www.merckmanuals.com/en-ca/professional/hematology-and-oncology/anemias-caused-by-hemolysis/thalassemias
• To, M., & Villatoro, V. (2019). Thalassemia – A Laboratory Guide to Clinical Hematology. Open Education Alberta. Retrieved March 12, 2024, from https://openeducationalberta.ca/mlsci/chapter/hypochromic-microcytic-anemias-thalassemias/Chronic Myelogenous Leukemia (CML)
• Cancer.Net Editorial Board. (2018, March). Leukemia - Chronic Myeloid - CML: Phases. Cancer.Net. Retrieved March 12, 2024, from https://www.cancer.net/cancer-types/leukemia-chronic-myeloid-cml/phases
• Emadi, A., & Law, J. Y. (2023, October). Chronic Myeloid Leukemia (CML) - Hematology and Oncology. Merck Manuals. Retrieved March 12, 2024, from https://www.merckmanuals.com/en-ca/professional/hematology-and-oncology/leukemias/chronic-myeloid-leukemia-cml
• To, M., & Villatoro, V. (2019). Chronic Myelogenous Leukemia (CML) – A Laboratory Guide to Clinical Hematology. Open Education Alberta. Retrieved March 12, 2024, from https://openeducationalberta.ca/mlsci/chapter/chronic-myelogenous-leukemia-cml/Cold Agglutinin Disease
• Braunstein, E. M. (2022, June). Autoimmune Hemolytic Anemia - Hematology and Oncology. Merck Manuals. Retrieved March 12, 2024, from https://www.merckmanuals.com/en-ca/professional/hematology-and-oncology/anemias-caused-by-hemolysis/autoimmune-hemolytic-anemia
• To, M., & Villatoro, V. (2019). Immune-Mediated Hemolytic Anemias. Open Education Alberta. Retrieved March 12, 2024, from https://openeducationalberta.ca/mlsci/chapter/immune-related-hemolytic-anemias/Hemolysis
• Braunstein, E. M. (2022, June). Overview of Hemolytic Anemia - Hematology and Oncology. Merck Manuals. Retrieved March 12, 2024, from https://www.merckmanuals.com/en-ca/professional/hematology-and-oncology/anemias-caused-by-hemolysis/overview-of-hemolytic-anemia
• Hemolytic Anemia. (n.d.). Boston Children's Hospital. Retrieved March 12, 2024, from https://www.childrenshospital.org/conditions/hemolytic-anemiaIron Deficiency Anemia
• Gerber, G. F. (2023, June). Iron Deficiency Anemia - Hematology and Oncology. Merck Manuals. Retrieved March 12, 2024, from https://www.merckmanuals.com/en-ca/professional/hematology-and-oncology/anemias-caused-by-deficient-erythropoiesis/iron-deficiency-anemia?query=iron%20deficiency%20anemia
• To, M., & Villatoro, V. (2019). Iron Deficiency Anemia (IDA) – A Laboratory Guide to Clinical Hematology. Open Education Alberta. Retrieved March 12, 2024, from https://openeducationalberta.ca/mlsci/chapter/hypochromic-microcytic-anemias-irond/Megaloblastic Anemia
• Gerber, G. F. (2023, June). Megaloblastic Macrocytic Anemias - Hematology and Oncology. Merck Manuals. Retrieved March 12, 2024, from https://www.merckmanuals.com/en-ca/professional/hematology-and-oncology/anemias-caused-by-deficient-erythropoiesis/megaloblastic-macrocytic-anemias
• To, M., & Villatoro, V. (2019). Megaloblastic Anemia – A Laboratory Guide to Clinical Hematology. Open Education Alberta. Retrieved March 12, 2024, from https://openeducationalberta.ca/mlsci/chapter/dna-metabolism-abnormalities-bone-marrow-failure-megaloblastic-anemia/Multiple Myeloma
• Berenson, J. R. (2023, June). Multiple Myeloma. Merck Manuals. Retrieved March 12, 2024, from https://www.merckmanuals.com/en-ca/professional/hematology-and-oncology/plasma-cell-disorders/multiple-myeloma?query=multiple%20myeloma#v976233
• To, M., & Villatoro, V. (2019). Plasma Cell Myeloma (Multiple Myeloma) – A Laboratory Guide to Clinical Hematology. Open Education Alberta. Retrieved March 12, 2024, from https://openeducationalberta.ca/mlsci/chapter/plasma-cell-myeloma-multiple-myeloma/Sickle Cell Disease
• Genetic and Rare Diseases Information Center. (n.d.). Sickle cell anemia - About the Disease. Genetic and Rare Diseases Information Center. Retrieved March 12, 2024, from https://rarediseases.info.nih.gov/diseases/8614/sickle-cell-anemia
• MedlinePlus. (2020, July 1). Sickle cell disease. MedlinePlus. Retrieved March 12, 2024, from https://medlineplus.gov/genetics/condition/sickle-cell-disease
• NHLBI. (2023, August 30). Sickle Cell Disease - What Is Sickle Cell Disease? NHLBI. Retrieved March 12, 2024, from https://www.nhlbi.nih.gov/health/sickle-cell-disease
• Timothy, G. G. (2008). Sickle Cell Disease. In Pediatric Emergency Medicine (pp. 898-904). Saunders/Elsevier. https://www.sciencedirect.com/science/article/abs/pii/B9781416000877501306
• To, M., & Villatoro, V. (2019). Sickle Cell (Hemoglobin SS) Disease – A Laboratory Guide to Clinical Hematology. Open Education Alberta. Retrieved March 12, 2024, from https://openeducationalberta.ca/mlsci/chapter/hemoglobinopathies-sickle-cell-hemoglobin-ss-disease/